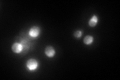
YNL061W
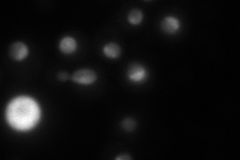
YNL061W
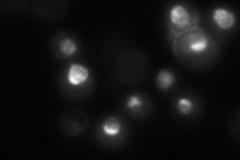
YNL061W

View description
Probable RNA m(5)C methyltransferase, essential for processing and maturation of 27S pre-rRNA and large ribosomal subunit biogenesis; localized to the nucleolus; constituent of 66S pre-ribosomal particles
Localization:
Intensity:
Fold change:
Significance:
-
C’ GFP library in SD
nucleus123.16 -
N' NOP1pr-GFP in SD

nucleolus146.822 -
N' TEF2pr-mCherry in SD
nucleus,nucleolus73.9791 -
N' NATIVEpr-GFP in SD
nucleus,nucleolus21.7471 -
N' TEF2pr-VC and Cyto-VN in SD

nucleus,nucleolus43.6542 -
C’ GFP library in SD+DTT

nucleus94.480.76No -
C’ GFP library in SD+H2O2

nucleus119.130.96No -
C’ GFP library in Starvation Media

punctateN/AN/AYes -
C’ GFP library on the background of Pup2-DaMP

N/A -
C’ GFP library on the background of CCT mutant

N/A0N/AYes
